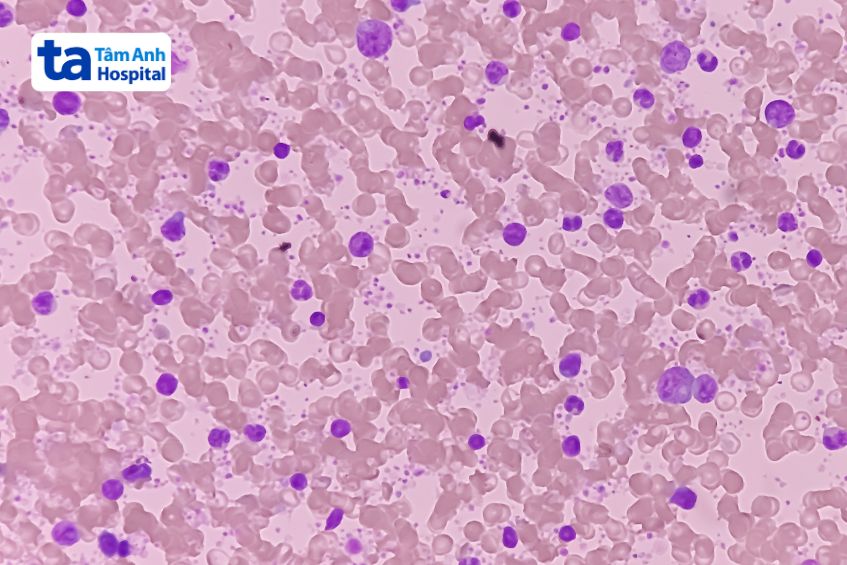
tăng tiểu cầu thứ phát trong máu

Tình trạng tăng tiểu cầu thứ phát hay tăng tiểu cầu phản ứng thường ít nguy hiểm, tuy nhiên nguyên nhân gây nên tình trạng này lại tiềm ẩn nhiều biến chứng. Vậy, tăng tiểu cầu thứ phát là gì? Chẩn đoán bệnh bằng cách nào?

Tăng tiểu cầu thứ phát (reactive thrombocytosis) là tình trạng số lượng tiểu cầu tăng cao tạm thời, xảy ra do các tác nhân cụ thể chẳng hạn như nhiễm trùng, chấn thương hoặc bệnh lý tiềm ẩn trong cơ thể. Nguyên nhân gây tăng tiểu cầu thứ phát có thể được xác định rõ ràng thông qua quá trình thăm khám, xét nghiệm.
Số lượng tiểu cầu ở người bệnh tăng tiểu cầu thứ phát thường dưới mức 1,000,000 tiểu cầu / mcL [1]. Khác với tăng tiểu cầu tiên phát, nguy cơ gây hình thành huyết khối hay xuất huyết của tình trạng tăng tiểu cầu thứ phát thường không đáng kể (trừ trường hợp mắc bệnh động mạch vành).
>> Tìm hiểu thêm về: Bệnh tăng tiểu cầu có nguy hiểm không?
Nguyên nhân tăng tiểu cầu thứ phát bắt nguồn từ việc:
Một số yếu tố nguy cơ dẫn đến tình trạng tăng tiểu cầu thứ phát phổ biến, bao gồm:
Ngoài ra, đột biến gen thrombopoietin có thể là yếu tố nguy cơ gây tăng tiểu cầu phản ứng [2]. Để xác định chính xác nguyên nhân, người bệnh cần sớm đến bệnh viện để khám và thực hiện một số xét nghiệm theo chỉ định của bác sĩ.
Tình trạng tăng tiểu cầu thứ phát ít tiềm ẩn nguy cơ hình thành huyết khối hoặc gây xuất huyết, triệu chứng thường không rõ ràng. Trong hầu hết các trường hợp, tình trạng tăng tiểu cầu thứ phát có xu hướng diễn biến âm thầm, không gây ra dấu hiệu bất thường. Vì vậy, mỗi người cần duy trì thói quen thăm khám sức khỏe định kỳ để sớm phát hiện bệnh và có biện pháp xử trí kịp thời, đặc biệt là người có các yếu tố nguy cơ gây tăng tiểu cầu thứ phát.
>> Tìm hiểu thêm: Tăng tiểu cầu có phải là ung thư máu?
Để chẩn đoán tình trạng tăng tiểu cầu, người bệnh cần đến bệnh viện để bác sĩ trực tiếp thăm khám. Thông qua quá trình thăm khám lâm sàng, bác sĩ sẽ ghi nhận triệu chứng đặc hiệu (nếu có), bệnh sử, thói quen sinh hoạt, quá trình sử dụng thuốc điều trị… Tiếp theo, để chẩn đoán chính xác tình trạng tăng tiểu cầu là thứ phát hay tiên phát, bác sĩ có thể chỉ định một số các xét nghiệm chuyên sâu, gồm:
Trường hợp kết quả xét nghiệm cho thấy người bệnh đang gặp phải tình trạng tăng tiểu cầu thứ phát, bác sĩ sẽ tiếp tục chỉ định người bệnh thực hiện thêm một số kỹ thuật để có đủ cơ sở chẩn đoán căn nguyên gây bệnh.
Kiểm soát tốt các bệnh lý gây tăng tiểu cầu thứ phát là yếu tố quan trọng giúp điều trị hiệu quả tình trạng này. Thông thường, tình trạng tăng tiểu cầu thứ phát sẽ được cải thiện sau khi điều trị căn nguyên gây bệnh. Người bị tăng tiểu cầu phản ứng cần tuân thủ phác đồ điều trị bệnh nền và chỉ định xét nghiệm máu định kỳ từ bác sĩ.

Việc chậm phát hiện tình trạng tăng tiểu cầu thứ phát là một trong những yếu tố ảnh hưởng đến hiệu quả điều trị, gây nguy hiểm cho sức khỏe của người bệnh. Tăng tiểu cầu thứ phát là dấu hiệu của sự tổn thương hoặc bệnh lý trong cơ thể.
Về cơ bản, tình trạng tăng tiểu cầu phản ứng thường lành tính, tuy nhiên căn nguyên gây nên tình trạng này (như bệnh ung thư, nhiễm trùng, thiếu máu…) tiềm ẩn nguy cơ dẫn đến các biến chứng nguy hiểm. Trong hầu hết các trường hợp, biến chứng của tăng tiểu cầu phản ứng không bắt nguồn từ tình trạng tăng số lượng tiểu cầu mà khởi phát do các rối loạn tiềm ẩn trong cơ thể không được phát hiện, điều trị kịp thời.
Người bệnh bị tăng tiểu cầu thứ phát cần lưu ý một số điều để đảm bảo sức khỏe, tối ưu hiệu quả chữa trị:
Để sớm phát hiện tình trạng tăng tiểu cầu, góp phần gia tăng cơ hội chẩn đoán và điều trị bệnh lý nguy hiểm tiềm ẩn trong cơ thể, mỗi người nên duy trì thói quen khám sức khỏe tổng quát định kỳ ít nhất 6 tháng / lần.
Đơn vị Huyết học lâm sàng, chuyên khoa Nội Tổng hợp tại Hệ thống Bệnh viện Đa khoa Tâm Anh, Tâm Anh Quận 7 chuyên thăm khám các bệnh lý về máu cũng như sức khỏe tổng quát toàn diện, ứng dụng máy móc hiện đại, đạt tiêu chuẩn quốc tế. Bệnh viện Tâm Anh đầu tư cơ sở tiện nghi, hiện đại với chi phí khám bệnh hợp lý,i quy tụ đội ngũ bác sĩ giàu kinh nghiệm trong khám và chữa trị các bệnh lý nội khoa.
Người bệnh có thể đăng ký thăm khám tình trạng tăng tiểu cầu tại Hệ thống Bệnh viện Đa khoa Tâm Anh, Tâm Anh Quận 7 qua:
HỆ THỐNG BỆNH VIỆN ĐA KHOA TÂM ANH
Tóm lại, bài viết đã cung cấp những thông tin cơ quản làm rõ hơn tình trạng tăng tiểu cầu thứ phát và các vấn đề liên quan. Mỗi người nên chủ động thăm khám sức khỏe định kỳ để sớm phát hiện các vấn đề sức khỏe tiềm ẩn trong cơ thể, trong đó có tình trạng tăng tiểu cầu phản ứng để sớm có biện pháp can thiệp, điều trị.